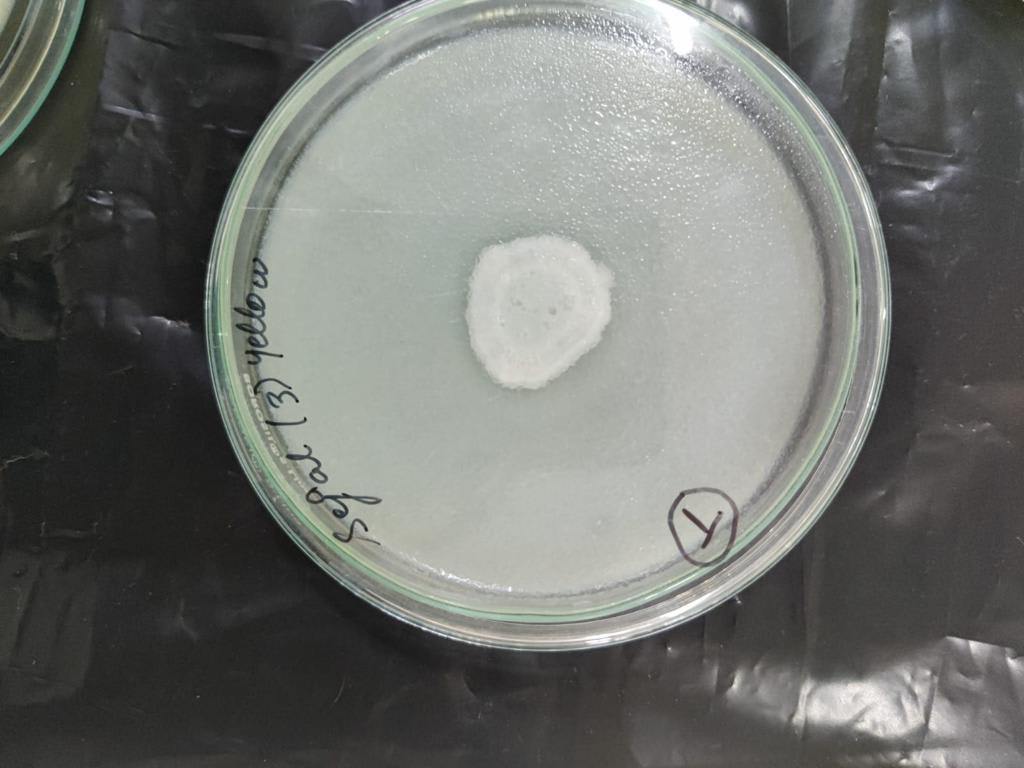
Microbiology experiments - Research Decode Consultancy Cover Image

Scientist
Dr Beena Kanwar Shekhawat
Scientific Writing
Rajasthan, India
1 Years
Joined Feb 2026
Swatantra Nirmal Foundation
Research
0 Consultations
About me
I am a Biotechnologist, have more than 5 year experince in higher education teaching. Since 2014 actively involved in research. 15+ year experince of school education specially Biology. CSIR-NET life science with AIR 27 and GATE qualified. Reciepient of national scholarships. publised good quality of research paper. Subject interest Biotechnology, Computational Biology, immunology, Microbiology, Molecular Biology, Biochemistry. Have one year teaching experience of paramedical course.
Interests: microbiology, molecular biology, Biochemistry
Skills
BiotechnologyGenomicsMicrobiologyMolecular BiologyEnzymology
Certifications
CSIR-NET life sciences